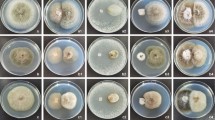

Abstract
Orchid mycorrhizal fungi are essential for the seed germination and vegetative growth of orchids. The orchid Bletilla striata has great medical value in China because its tuber is rich in mannan. Some endophytic fungi were isolated from the roots of B. striata. The isolate KB-3 was selected for experiments because it could promote the germination of B. striata seeds. Based on morphological characters and phylogenetic analysis, the isolate KB-3 was identified as Fusarium oxysporum. Co-cultivation experiments of KB-3 with B. striata and Dendrobium candidum were performed to demonstrate orchid mycorrhizal structures. Microscopic examination showed that KB-3 established colonization and produced coiled hyphal structures known as pelotons within the cortical cells of both orchid roots. The results confirm that F. oxysporum KB-3 can behave as an orchid mycorrhizal fungus.
Similar content being viewed by others
Avoid common mistakes on your manuscript.
Introduction
The Orchid family, which contains more than 25,000 species in 780 genera, is one of the largest plant families (Jones 2006). Various orchid species are widely used as herbal medicines including Bletilla striata and Dendrobium candidum. The tuber of B. striata is rich in mannan so that this orchid plant has been used in the treatment of hemoptysis and hemorrhage from gastric ulcer and trauma (Bulpitt et al. 2007). Orchid seeds contain few nutrient reserves due to their small size. Compatible mycorrhizal fungal species are therefore necessary to provide nutrients to germinating orchid seeds for the development of the protocorm and further differentiation of the root, stem, and leaf (Rasmussen 1995; Yeung 2017). Mycorrhizal fungi assist orchid plants to improve water and nutrient uptake, plant growth, toxin endurance, and disease resistance while forming coiled hyphal structures known as pelotons within cortical cells (Yao et al. 2002; Artursson et al. 2006; Smith and Read 2008; Ding et al. 2014). These symbiotic relationships are essential for the survival of orchids throughout all life stages (Zhao et al. 2014).
Mycorrhizal fungi can penetrate and colonize orchids at all stages of their life cycle (Rafter et al. 2016; Dearnaley et al. 2016). The fungal hyphae enter the roots mostly by penetration through root hairs or directly through the epidermis in some epiphytic orchid species (Sathiyadash et al. 2012; Williamson and Hadley 1970). Different from arbuscules formed by arbuscular mycorrhizal fungi, hyphae of orchid mycorrhizal fungi coil up tightly to form hyphal pelotons, which can occupy the whole plant cell. Subsequently, pelotons senesce and collapse, and the host cell can digest the fungal structures and retain its nutrients (Dearnaley et al. 2016).
Identification of orchid mycorrhizal fungi was usually difficult due to the lack of teleomorph stage of isolates (Andersen and Rasmusen 1996), and isolates obtained by regular isolation methods may actually be saprotrophs or pathogens (McCormick et al. 2004). DNA barcoding techniques made it possible to accurately identify fungi from pure cultures or directly from orchid tissue without the isolation process (Dearnaley et al. 2013). Most of the known orchid mycorrhizal fungi are “Rhizoctonia like fungi” in Basidiomycota such as Ceratobasidiaceae, Tulasnellaceae, and Serendipitaceae (Weiß et al. 2016). Some species of Ascomycetes may be potentially mycorrhizal fungi in orchid roots. Up to now, seven new species of Colletotrichum spp. (Colletotrichum bletillum, C. caudasporum, C. duyunensis, C. endophytum, C. excelsum-altitudum, C. guizhouensis, and C. ochracea) have been reported as endophytes from Bletilla ochracea root tissue (Tao et al. 2013). However, few fungi have been reported as mycorrhizal fungus from Bletilla root specifically because co-incubation of potential fungi with orchid seedlings (Bidartondo et al. 2004), seeds, or mature orchid plants is required to confirm the mycorrhizal colonization. Understanding the specificity of the fungal-orchid symbiotic association is essential for orchid cultivation and conservation, however, little is known about the compatibility between various fungal species and orchid species. Sporadic studies showed that some orchids require certain fungal species for seed germination. Such specificity was observed for Mycena anoectochila, M. orchidicola, and M. dendrobii, which were beneficial for Anoectochilus roxburghii, but could not promote seed germination of Dendrobium (Liu et al. 2010). As the orchid plant develops and the root ages, a switch of fungal partner in the fungal symbiont may happen (Dearnaley 2007) and the specificity may become less stringent (Bayman et al. 2016; Hadley 1970). Mycorrhizal fungi can promote the vegetative growth of the mature orchid plant (Liu et al. 2010) or even other non-orchid plants, such as the Serendipita indica, which is a plant growth-promoting fungus with significant potential in crop production (Weiß et al. 2016; Varma et al. 2012).
Many wild orchid species are endangered because of unsustainable harvest for the orchid trade as well as the loss of habitat. To conserve the orchid species in the wild, farm-based cultivation of B. striata is a rising industry in China. Therefore, a full understanding of the symbiosis and identifying the mycorrhizal fungal partners of B. striata is essential to improve its cultivation and to protect the wild B. striata resource. The objectives of this study are (1) to isolate and identify mycorrhizal fungi associated with B. striata and (2) to characterize the colonization of a GFP-transformed mycorrhizal fungus in orchid roots.
Materials and methods
Fungal isolation and morphological identification
Bletilla striata samples were collected from Zhongxiang County, Hubei Province, China (31° 09′ N, 112° 39′ E, altitude 500 m) in July 2015. A modified single peloton isolation method was used to isolate the mycorrhizal fungi (Warcup and Talbot 1967). B. striata roots were rinsed with running water for 20 min, surface-sterilized with 75% ethanol for 90 s and 2% NaOCl for 3 min, then rinsed in sterilized water for 3 times. Surface sterilized roots were transferred to autoclaved glass slides and then sliced into segments of 0.1–1 mm × 1 cm in length under a dissecting microscope. After microscopic examination, segments with ellipsoid hyphal coils (pelotons) were transferred to an autoclaved 1.5-mL centrifuge tube with 300 μL sterilized water, then vortexed for 10 min to release the pelotons. The peloton suspensions were dispensed and spread onto potato dextrose agar (PDA) with gentamicin (100 μg/mL), and chloramphenicol (17 μg/mL), then incubated at 28 °C. After five to seven days, hyphal tips were transferred to new PDA plates for purification. Purified mycelia were transferred to PDA plates and incubated at 28 °C for three days. Sporulation of the isolates was induced on carnation leaf agar (CLA) at 28 °C for seven days. Plates were exposed to ultraviolet radiation for 2 h on the fourth day to stimulate sporulation. Nine Fusarium spp. and one Rhizoctonia sp. were obtained from the isolation process. A representative Fusarium sp. isolate KB-3 was selected for further research because of its seed germination-promoting potential in the preliminary experiment (Fig. 1a).
Molecular identification and phylogenetic analysis
The pure culture of KB-3 was inoculated on PDA plates at 28 °C for seven days to extract the total genomic DNA using the CTAB method (Stenglein and Balatti 2006). Total DNA products were dissolved in 50 μL of distilled deionized water and stored at − 20 °C. The fungal internal transcribed spacer region of chromosomal DNA sequence (rDNA-ITS) and the translation elongation factor (EF1α) of KB-3 were amplified with primer pair ITS4/ITS5 (White et al. 1990) and EF1-728F/EF1-986R (Carbone and Kohn 1999).
The PCR reactions were performed with 20 μL reaction volumes (3 μL gDNA, 10 μM forward primer, 10 μM reverse primer, 2 × PCR Master Mix (Takara, Japan)) in GeneAmpR PCR System 2700 (Applied Biosystems, USA) under the following program: 94 °C for 2 min, 30 cycles of denaturation at 94 °C for 40 s, annealing at 55 °C for ITS and 58 °C for EF1 for 60 s, extension at 72 °C for 60 s, and final extension at 72 °C for 10 min. The amplicons were sequenced (SinoGenoMax, China) then deposited in the GenBank nucleotide database (accession numbers MF457482 and MK138899). Additional sequences were retrieved from GenBank (Table 1 in the ESM). All the sequences were aligned with the online tool MAFFT (http://www.ebi.ac.uk/Tools/msa/mafft/) (Katoh and Toh 2010). Neocosmospora solani CBS 140079 was used as an outgroup in the phylogenetic analysis with PAUP v4.0b10 (Swofford 2003). Unweighted parsimony (UP) analysis was performed. Trees were inferred using the heuristic search option with TBR branch swapping and 1000 random sequence additions, branches of zero length were collapsed and all equally, most parsimonious trees were saved. Tree length (TL), consistency index (CI), retention index (RI), and rescaled consistency index (RC) were calculated for the generated parsimony trees. The models of evolution were estimated by using MrModeltest v.2.3 (Nylander 2004). The final phylogenetic tree was viewed and edited in FigTree 1.43.
Protoplasts and plasmids preparation
The protoplasts of isolate KB-3 were prepared using the method described by Vollmer and Yanofsky (1986) with minor modifications. The fungi were cultured in 200 mL potato-dextrose broth (PDB) at 28 °C with vortex at 120 rpm/min for 48 h. Mycelia were filtered with three layers of sterilized lens paper, rinsed with sterile 0.8 M NaCl then transferred to a sterile 50-mL centrifuge tube on ice. The lysing enzymes (200 mg driselase and 100 mg lywallzyme) were added into the tube at 30 °C, 80 rpm/min., and incubated for 3.5 h. The liquid was filtered through three layers of sterilized lens paper to collect the released protoplast. The filtrate was centrifuged for 10 min at room temperature, 3000 rpm/min. The pelleted protoplasts were re-suspended with 20 mL STC solution (1.2 M sorbitol, 50 mM Tris-HCl (pH 8.0), and 50 mM CaCl2) and centrifuged again for 10 min at 4 °C, 5000 rpm/min. Protoplasts were re-suspended and adjusted to 2–5 × 107/mL with STC solution. E. coli, which harbors pCT74 plasmid with the GFP gene, hygromycin B resistance gene, and the ToxA promoter of Pyrenophora tritici-repentis (Freitag et al. 2001; Lorang et al. 2001), was incubated overnight at 37 °C in 50 mL LB broth with 50 μg/mL ampicillin. Plasmid DNA was harvested using Mini Plasmid DNA Extract Kit (OMEGA) following the manufacturer’s manual and confirmed by 1% agarose gel electrophoresis.
Fungal transformation
In a sterile 50-mL disposable centrifuge tube, 1 mL of protoplast solution was gently mixed with 10–20 μg pCT74 plasmid, 25 μL 2 × STC solution, and 25 μL 60% PEG 4000 solution and incubated on ice for 20 min. A total of 1.2 mL of 40% PTC solution was added into the tube. After 20 min on ice, 4 mL STC solution was added into the tube with gently turning upside down to induced cell wall reviving at 28 °C, 90 rpm/min for 10–15 h. Thereafter, 100 μL of the solution was transferred to PDA media with 150 μg/L hygromycin B and 50 μg/L ampicillin (amp). After incubation at 28 °C for four to seven days, resistant colonies were checked by microscopic examination with a fluorescence microscope (SUNNY XY-RFL) and 488 nm blue excitation light. Transformants cultured on PDA and CLA plates supplemented with 150 μg/L hygromycin B were examined for the morphological and cultural characteristics.
The colonization and growth promoting effects of KB-3 in orchid plants
To prepare the growth substrate, peat and humic soil were mixed by the volume ratio of 1: 1 and then autoclaved at 121 °C, 110 KPa for 2 h. KB-3 transformant was inoculated into 200 mL PDB and incubated at 28 °C for seven days, then centrifuged at 3000 rpm for 10 min to collect the mycelia. Mycelia were re-suspended with 200 mL sterilized water and mixed with the substrate. Substrate for the control group was mixed with 200 mL sterilized water. Five pots (2.5 L) were filled with 2 L substrate for the treatment and control group. B. striata tissue-culture seedlings at a similar growth stage were gently rinsed with sterile water. Plant roots were wounded with sterilized insect needle and soaked in 1.0 × 106/mL KB-3 transformant spore suspension for 60 min. The roots of the control group were wounded with sterilized insect needle and soaked in sterilized water for 60 min. Four seedlings were planted in each pot, 20 seedlings were planted in total for each group. All plants were cultured in a growth chamber (25 °C, 12 h day/night photoperiod, 3500 lx). Sixty days later, 15 seedlings were randomly selected from the experimental groups for the measurement. The aboveground part of the plant was cleaned to measure the height and fresh weight. Thereafter, biomass was dried at 40 °C for 36 h to measure the dry weight. Statistical analysis (t test) of the treatment and control groups were performed in R, graphs were generated in SigmaPlot 14 (Systat Software, Inc., USA).
Twenty Dendrobium candidum seedlings were inoculated as described above to visualize the fungal colonization. Three B. striata and D. candidum plants from the experimental groups were randomly selected for microscopic examination. The roots were gently washed with a sponge in sterilized water then were soaked in 70% alcohol for 1 h. The roots were manually sliced to sections (30–100 μm) under a dissecting microscope. Sections were observed with 488 nm blue excitation light by a fluorescence microscope (SUNNY XY-RFL). For bright field microscopic observation, the root sections with green fluorescence were soaked in 2.5% KOH for 2 h at room temperature, rinsed with sterile water for three times, and dried with autoclaved paper towel. After immersion in 5 M HCl for 10 min, root sections were stained with 0.05% trypan blue solution for 30 mins and examined in bright field under a microscope (SUNNY XY-RFL).
Results
Morphological and molecular identification of isolate KB-3
After three days incubation of isolate KB-3 on PDA media at 28 °C, colonies were white to grayish-violet with white, floccose aerial hyphae. Macroconidia were long, straight to falcate, dorso-ventral sides, hyaline, three to four septate, 30.09 ± 3.80 μm long × 3.708 ± 0.39 μm wide (n = 26). Microconidia were formed abundantly on long and short monophialides oval to obovate, zero to one septate, 11.94 ± 4.37 μm long × 3.05 ± 0.44 μm wide (n = 39) (Fig. 1). The morphological characteristics were identical to the previous description of F. oxysporum.
The ITS and EF1 sequences are 557 bp and 284 bp respectively. The BLAST search results showed these sequences are 100% and 99% identical to the sequences of multiple F. oxysporum isolates. The combined dataset of ITS and TEF1 included 45 sequences and consisted of 1260 total characters, of which 760 characters are constant, 103 variable characters are parsimony uninformative, and 397 characters are parsimony-informative. The most parsimonious analysis generated three equally parsimonious trees, the one with shortest tree length (TL = 1189, CI = 0.631, RI = 0.831, RC = 0.524, HI = 0.369) was displayed in Fig. 2. Isolate KB-3 located on the same clade of multiple endophytic or pathogenic F. oxysporum isolates.
The transformation of F. oxysporum KB-3
One transformant which expressed GFP constitutively was retained for subsequent experiments. The hyphae, macroconidia, and microconidia fluoresced bright green under the fluorescence microscope (Fig. 3). The morphological characters of the colonies and spores are identical with the wild-type isolate KB-3.
The transformation of isolate KB-3. a Colony of fungal wild type. b Colony of GFP-transformant. c, e Bright-field microscopic images of (c) micro- and macro- conidia and (e) hyphae. d, f Fluorescence microscopic images with 488 nm blue excitation light of GFP-transformant (d) micro- and macro- conidia and (f) hyphae, (bars = 20 μm)
Growth promoting effect of endomycorrhizal F. oxysporum KB-3 in B. striata
After 60 days of incubation, B. striata from the treatment group, which was co-cultivated with F. oxysporum KB-3, showed significant increase in height, fresh weight, and dry weight (all P values < 0.001) compared to the control group, which was mock-inoculated with sterilized water (Fig. 4). The result indicated a significant plant growth promoting effect of F. oxysporum KB-3.
The growth promoting effect of B. striata inoculated with the KB-3 GFP-transformant after 60 days. aB. striata were inoculated with the KB-3 GFP transformant (left) and with sterile water (right). (b, c) the effect of the KB-3 GFP-transformant on the height (b) and weight (c) of B. striata (all P values < 0.001)
Colonization of F. oxysporum KB-3 in B. striata and D. candidum
Root sections of B. striata roots inoculated with the KB-3 transformants were observed under the SUNNY XY-RFL fluorescence microscope. Roots of the plantlets showed massive pelotons in the cortex cells (Fig. 5). The sections inoculated with transformants showed that many subsphaeroidal pelotons colonizing inside the cortex cells emitted bright green fluorescence under 488 nm blue excitation light (c, d), but the control had no hyphal pelotons so that no fluorescence spot occurred inside in the cortex cells (a, b). Transverse sections containing pelotons stained with trypan blue indicated that blue hypha entered roots through root hairs to eventually colonize and form hyphal pelotons in the cortical cells (e, f). At first, when an external hypha entered a root hair (black arrowheads), it continued to grow along the root hair into epidermal cells (e). Afterward, the mycelia developed and stretched crookedly from cell to cell until colonizing and forming pelotons (black arrowheads) in cortical cells of the roots of B. striata (f), pelotons in adjacent cells were connected by a winding hypha.
B. striata root colonization by the KB-3 GFP-transformant 60 days after inoculation. a, bB. striata root section of the control group in bright-field (a) and fluorescence microscopy (b), and c, d fungal pelotons in the root section of B. striata inoculated with GFP transformant in bright-field (c) and fluorescence microscopy (d). e Penetration of KB-3 GFP-transformant through root hair (arrow) and the development in cortex and epidermal cells stained with trypan blue. f Pelotons (arrows) in root cells stained with trypan blue (a–d, 100 ×, bar = 200 μm; e–f, 200 ×, bar = 20 μm)
Similar to B. striata, large numbers of pelotons and typical orchid mycorrhizal structures were observed in the root cortex cells of D. candidum inoculated with the transformants in vitro (Fig. 6). These pelotons could emit bright green fluorescence under 488 nm blue excitation light (c, d), but the control had no pelotons so that no fluorescence spot occurred inside in the cortex cells (a, b). After staining with trypan blue, transverse sections illustrated that the hyphae penetrated through the wall of cortical cells and continuously spread inward, then formed deep-colored pelotons in the center of cortical cells (e, f).
Dendrobium candidum root colonization by KB-3 GFP-transformant 60 days after inoculation. a, bD. candidum root section of the control group in bright-field (a) and fluorescence microscopy (b). c, d Fungal pelotons in the root section of D. candidum inoculated with GFP transformant in bright-field (c) and fluorescence microscopy (d). e, f Pelotons in root cells stained with trypan blue (a–d, 100 ×, bar = 200 μm, e: 200×, bar = 20 μm, f: 400×, bar = 10 μm)
Discussion
In this study, a non-pathogenic mycorrhizal fungal isolate was collected from the roots of a wild B. striata. The isolate was identified as F. oxysporum based on morphology and molecular phylogenetic analysis. After successful transformation of the isolate with the GFP gene, transformants were co-cultured with two orchid species, B. striata and D. candidum. The results showed that isolate KB-3 significantly promoted the vegetative growth of both orchid species; typical orchid mycorrhizal structures were observed in their roots.
Basidiomycetes are more commonly reported as orchid mycorrhiza than ascomycetes (Rasmussen 2002; Dearnaley 2007), though various pezizalean ascomycetes species have been reported as mycorrhizal fungi from Epipactis spp. (Tesitelova et al. 2012). Several Fusarium spp. isolates have been reported to stimulate seed germination in the terrestrial orchid Cypripedium reginae (Vujanovic et al. 2000) to promote seedling growth and to form endomycorrhiza in Eulophia alta (Johnson et al. 2007), Cattleya skinneri, and Brassavola nodosa (Ovando et al. 2005), but detailed identification of these isolates was not achieved. The F. oxysporum species complex includes plant pathogens, opportunistic human pathogens, plant endophytes, and plant saprophytes (Laurence et al. 2014). In orchid roots, pathogenic F. oxysporum has been reported as the causal agent of root rot in Cymbidium orchids (Benyon et al. 1996). F. oxysporum has also been reported as an endophyte from a threatened terrestrial orchid Pecteilis susannae (L.) Rafin based on sequencing of ITS amplicons, pure cultures were not obtained to confirm the mycorrhizal status of F. oxysporum in co-incubation essays with this orchid (Chutima et al. 2011). Similar as other orchid mycorrhizal fungi (Sathiyadash et al. 2012; Williamson and Hadley 1970), the hyphae of F. oxysporum KB-3 also entered the B. striata roots by penetration through root hairs then formed pelotons within cortex cells.
The application of the fluorescent protein transformation technique in fungi allows studying the fungal cell dynamics and visualizes the fungi in host-parasite interactions (Lorang et al. 2001). Fungal strains tagged with this fluorescent protein have previously been used in many arbuscular mycorrhizal fungi to study the colonization within the plant tissue (Pimprikar et al. 2016; Genre et al. 2008). The GFP-transformation of an orchid mycorrhizal fungus has not been reported yet. The successful fungal transformation in this work demonstrated that GFP-labeled F. oxysporum KB-3 could be a useful tool to study the symbiont development and plant–fungus interactions between orchids and their mycorrhizal fungi.
The specificity between mycorrhizal fungi and orchid species is controversial. In terrestrial orchids, several recent studies indicated that the specificity between fungi and orchid species was age-related, certain fungal species might be required for orchid seed germination and seedling development, but more fungal species could be compatible with the adult plant (Bayman et al. 2016; Waud et al. 2017; Liu et al. 2010). In some orchid species such as the Cypripedium spp., high specificity of fungi-orchid association is still required throughout all development stages of the orchid life cycle (Shefferson et al. 2005). Therefore, the compatibility of specific fungi and orchid species and the mechanism of recognition between these two components require further investigation. Switching the plant host of mycorrhizal fungus from Anoectochilus roxburghii, Cymbidium sinense, and Dendrobium officinale to B. striata for seed germination promoting purpose was not successful (Liu et al. 2010). Here, a mycorrhizal fungus from B. striata could colonize D. candidum roots. This result indicated that some mycorrhizal fungi could be cross-utilized between terrestrial orchid (B. striata) and epiphytic orchids (D. candidum).
References
Andersen TF, Rasmusen HN (1996) The mycorrhizal species of Rhizoctonia. Rhizoctonia, species: taxonomy, molecular biology, ecology, Pathology and disease control. Springer, Dordrecht, pp 379–390
Artursson V, Finlay RD, Jansson JK (2006) Interactions between arbuscular mycorrhizal fungi and bacteria and their potential for stimulating plant growth. Environ Microbiol 8:1–10
Bayman P, Mosqueraespinosa AT, Saladiniaponte CM, Hurtadoguevara NC, Vieraruiz NL (2016) Age-dependent mycorrhizal specificity in an invasive orchid, Oeceoclades maculata. Am J Bot 103:1880–1889
Benyon F, Summerell BA, Burgess LW (1996) Association of Fusarium species with root rot of Cymbidium orchids. Australas Plant Pathol 25:226
Bidartondo MI, Burghardt B, Gebauer G, Bruns TD, Read DJ (2004) Changing partners in the dark: isotopic and molecular evidence of ectomycorrhizal liaisons between forest orchids and trees. Proc R Soc B Biol Sci 271:1799–1806
Bulpitt CJ, Li Y, Bulpitt PF, Wang J (2007) The use of orchids in Chinese medicine. J R Soc Med 100:558–563
Carbone I, Kohn LM (1999) A method for designing primer sets for speciation studies in filamentous ascomycetes. Mycologia 91:553–556
Chutima R, Dell B, Vessabutr S, Bussaban B, Lumyong S (2011) Endophytic fungi from Pecteilis susannae (L.) Rafin (Orchidaceae), a threatened terrestrial orchid in Thailand. Mycorrhiza 21:221–229
Dearnaley JDW (2007) Further advances in orchid mycorrhizal research. Mycorrhiza 17:475–486
Dearnaley JDW, Martos F, Selosse M-A (2013) Orchid mycorrhizas: molecular ecology, physiology, evolution and conservation aspects. In: Hock B (ed) The Mycota IX: fungal associations. Springer, Berlin, pp 207–230
Dearnaley JWD, Perotto S, Selosse M-A (2016) Structure and development of orchid mycorrhizas. In: Martin F (ed) Molecular mycorrhizal symbiosis. Wiley-Blackwell, Hoboken, pp 63–86
Ding R, Chen XH, Zhang LJ, Yu XD, Qu B, Duan R, Xu YF (2014) Identity and specificity of Rhizoctonia-like fungi from different populations of Liparis japonica (Orchidaceae) in Northeast China. PLoS One 9:e105573
Freitag M, Ciuffetti LM, Selker EU (2001) Expression and visualization of green fluorescent protein (GFP) as a reporter gene for the plant pathogenic oomycete Phytophthora palmivora. FEMS Microbiol Lett 178:71–80
Genre A, Chabaud M, Faccio A, Barker DG, Bonfante P (2008) Prepenetration apparatus assembly precedes and predicts the colonization patterns of arbuscular mycorrhizal fungi within the root cortex of both Medicago truncatula and Daucus carota. Plant Cell 20:1407–1420
Hadley G (1970) Non-specificity of symbotic infection in orchid mycorrhiza. New Phytol 69:1015–1023
Johnson TR, Stewart SL, Dutra D, Kane ME, Richardson L (2007) Asymbiotic and symbiotic seed germination of Eulophia alta (Orchidaceae) – preliminary evidence for the symbiotic culture advantage. Plant Cell Tissue Org Cult 90:313–323
Jones DL (2006) A complete guide to native orchids of Australia including the island territories. Reed New Holland, Sydney, pp 418–419
Katoh K, Toh H (2010) Parallelization of the MAFFT multiple sequence alignment program. Bioinformatics 26(15):1899–1900
Laurence MH, Summerell BA, Burgess LW, Liew EC (2014) Genealogical concordance phylogenetic species recognition in the Fusarium oxysporum species complex. Fungal Biol 118:374–384
Liu H, Luo Y, Liu H (2010) Studies of mycorrhizal fungi of Chinese orchids and their role in orchid conservation in China-a review. Bot Rev 76:241–262
Lorang JM, Tuori RP, Martinez JP, Sawyer TL, Redman RS, Rollins JA, Wolpert TJ, Johnson KB, Rodriguez RJ, Dickman MB, Ciuffetti LM (2001) Green fluorescent protein is lighting up fungal biology. Appl Environ Microb 67:1987–1994
McCormick MK, Whigham DF, O’Neill J (2004) Mycorrhizal diversity in photosynthetic terrestrial orchids. New Phytol 163:425–438
Nylander JAA (2004) MrModeltest, version 2.1. Evolutionary Biology Centre, Uppsala University, Uppsala. Program distributed by the author. http://www.abc.se/~nylander/
Ovando I, Damon A, Bello R, Ambrosio D, Albores V, Adriano L, Salvador M (2005) Isolation of endophytic fungi and their potential for the tropical epiphytic orchids Cattleya skinneri, C. aurantiaca and Brassavola nodosa. Asian J Plant Sci 4:309–315
Pimprikar P, Carbonnel S, Paries M, Katzer K, Klingl V, Bohmer MJ, Karl L, Floss DS, Harrison MJ, Parniske M, Gutjahr C (2016) A CCaMK-CYCLOPS-DELLA complex activates transcription of RAM1 to regulate arbuscule branching. Curr Biol 26:987–998
Rafter M, Yokoya K, Schofield EJ, Zettler LW, Sarasan V (2016) Non-specific symbiotic germination of Cynorkis purpurea (Thouars) Kraezl, a habitat-specific terrestrial orchid from the central highlands of Madagascar. Mycorrhiza 26:541–552
Rasmussen HN (1995) Terrestrial orchids - from seed to mycotrophic plant. Cambridge University Press, Cambridge 444 pp
Rasmussen HN (2002) Recent developments in the study of orchid mycorrhiza. Plant Soil 244:149–163
Sathiyadash K, Muthukumar T, Uma E, Pandey RR (2012) Mycorrhizal association and morphology in orchids. J Plant Interact 7:238–247
Shefferson RP, Wei M, Kull T, Taylor DL (2005) High specificity generally characterizes mycorrhizal association in rare lady’s slipper orchids, genus Cypripedium. Mol Ecol 14:613–626
Smith SE, Read DJ (2008) Mycorrhizal symbiosis. Academic, London
Stenglein SA, Balatti PA (2006) Genetic diversity of Phaeoisariopsis griseola in Argentina as revealed by virulence and molecular markers. Physiol Mol Plant Pathol 68:158–167
Swofford DL (2003) PAUP. Phylogenetic analysis using parsimony (and other methods). Version 4. Sinauer Associates, Sunderland
Tao G, Liu ZY, Liu F, Gao YH, Cai L (2013) Endophytic colletotrichum species from Bletilla ochracea (Orchidaceae), with descriptions of seven new speices. Fungal Divers 61:139–164
Tesitelova T, Tesitel J, Jersakova J, Rihova G, Selosse MA (2012) Symbiotic germination capability of four Epipactis species (Orchidaceae) is broader than expected from adult ecology. Am J Bot 99:1020–1032
Varma A, Bakshi M, Lou B, Hartmann A, Oelmueller R (2012) Piriformospora indica: a novel plant growth-promoting mycorrhizal fungus. Agric Res 1:117–131
Vollmer SJ, Yanofsky C (1986) Efficient cloning of genes of Neurospora crassa. Proc Natl Acad Sci U S A 83:4869–4873
Vujanovic V, Starnaud M, Barabe D, Thibeault G (2000) Viability testing of orchid seed and the promotion of colouration and germination. Ann Bot 86:79–86
Warcup JH, Talbot PHB (1967) Perfect states of Rhizoctonias associated with orchids. New Phytol 66:631–641
Waud M, Brys R, Van Landuyt W, Lievens B, Jacquemyn H (2017) Mycorrhizal specificity does not limit the distribution of an endangered orchid species. Mol Ecol 26:1687–1701
Weiß M, Waller F, Zucaro A, Selosse M-A (2016) Sebacinales — one thousand and one interactions with land plants (Tansley review). New Phytol 211:20–40
White TJ, Bruns T, Lee S, Taylor J (1990) Amplification and direct sequencing of fungal ribosomal RNA genes for phylogenetics. In: Innis MA, Gelfand DH, Sninsky JJ (eds) PCR protocols: a guide to methods and applications. Academic, Cambridge, pp 315–322
Williamson B, Hadley G (1970) Penetration and infection of orchid protocorms by thanatephorus cucumeris and other rhizoctonia isolates. Phytopathology 60:1092
Yao MK, Tweddell RJ, Désilets H (2002) Effect of two vesicular-arbuscular mycorrhizal fungi on the growth of micropropagated potato plantlets and on the extent of disease caused by Rhizoctonia solani. Mycorrhiza 12:235–242
Yeung EC (2017) A perspective on orchid seed and protocorm development. Bot Stud 58:33
Zhao X, Zhang J, Chen C, Yang J, Zhu H, Liu M, Lv F (2014) Deep sequencing-based comparative transcriptional profiles of cymbidium hybridum, roots in response to mycorrhizal and non-mycorrhizal beneficial fungi. BMC Genomics 15:747–747
Funding
This study is funded by the National Key Research and Development Program (2017YFD0201106), the Natural Science Fund of Education Department of Hubei province (D20181304), and the vegetable fertilizer and pesticide reducing team project of Hubei province.
Author information
Authors and Affiliations
Contributions
JJ executed all experiments except phylogenetic analysis and wrote the draft, KZ did the phylogenetic analysis and manuscript writing, ZS and YZ designed the experiments.
Corresponding authors
Additional information
Publisher’s note
Springer Nature remains neutral with regard to jurisdictional claims in published maps and institutional affiliations.
Electronic supplementary material
ESM 1
(DOCX 636 kb)
Rights and permissions
About this article
Cite this article
Jiang, J., Zhang, K., Cheng, S. et al. Fusarium oxysporum KB-3 from Bletilla striata: an orchid mycorrhizal fungus. Mycorrhiza 29, 531–540 (2019). https://doi.org/10.1007/s00572-019-00904-3
Received:
Accepted:
Published:
Issue Date:
DOI: https://doi.org/10.1007/s00572-019-00904-3